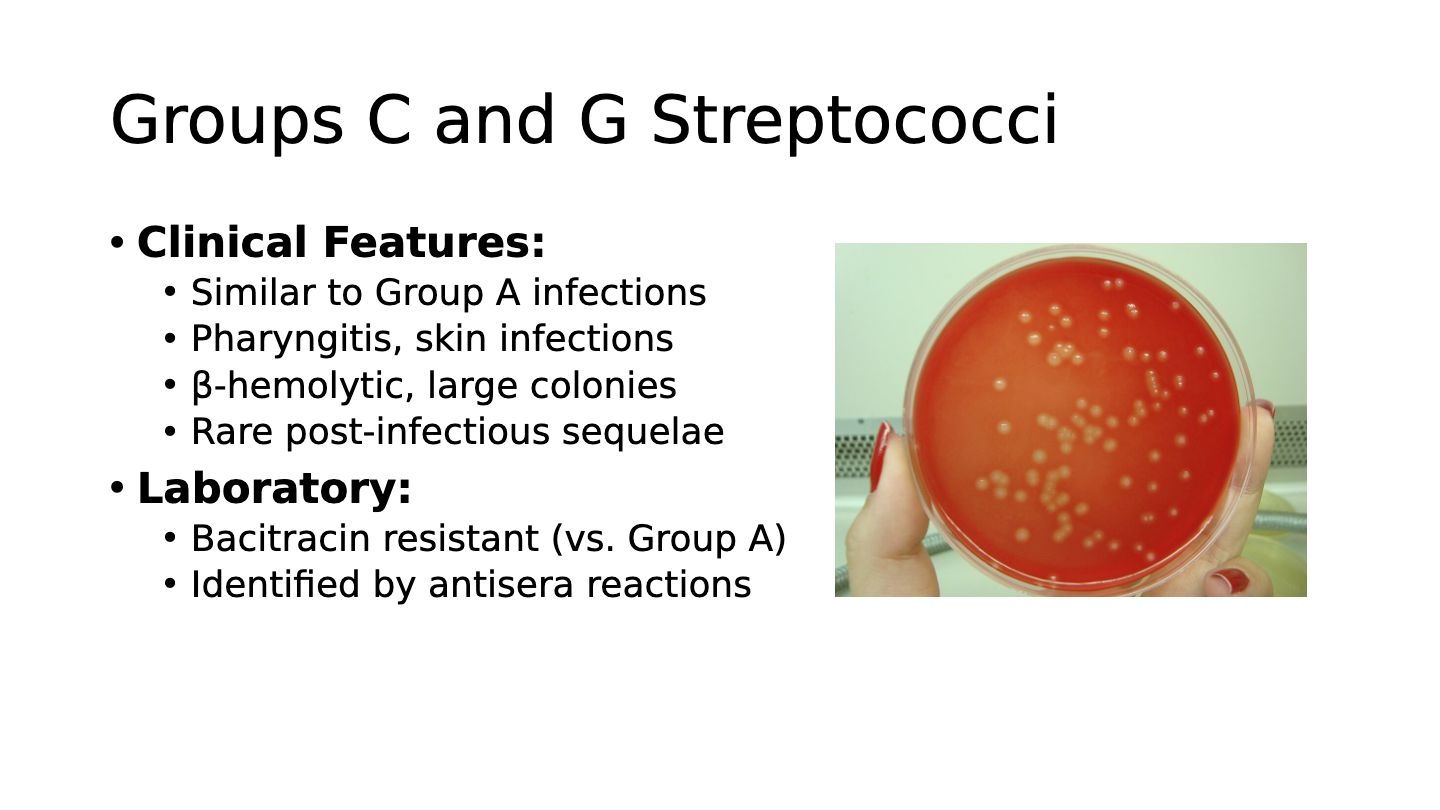
media

Streptococci, Enterococci
Presentation
•
Science
•
Professional Development
•
Hard
Wengel Araya
FREE Resource
51 Slides • 28 Questions
1

2

3
Multiple Choice
Which of the following is a leading cause of community-acquired pneumonia?
Streptococcus pyogenes
Streptococcus pneumoniae
Enterococcus faecalis
Viridans streptococci
4
Open Ended
Why is it important for pharmacists to understand the clinical relevance of streptococci and enterococci infections?
5

6

7
Multiple Choice
Which of the following is NOT a key characteristic of gram-positive cocci?
Form pairs or chains during growth
Catalase-negative
Gram-negative spherical bacteria
Widely distributed in nature
8

9
Multiple Choice
Why are multiple classification systems used for streptococci?
Because one system is universally accepted
Because streptococci are a large, heterogeneous group
Because all species have the same characteristics
Because taxonomy is fixed and unchanging
10

11
Open Ended
Describe the visual differences between beta, alpha, and gamma hemolysis patterns on blood agar.
12

13
Multiple Choice
Which of the following groups is correctly matched with its clinical association according to the Lancefield classification?
Group A - Neonatal infections
Group B - Strep throat
Group C & G - Pharyngitis
Group D - Pharyngitis
14

15
Multiple Select
Select all correct statements about hemolysis patterns and clinical groups of streptococci.
Pyogenic streptococci are beta-hemolytic
Viridans group are alpha-hemolytic or non-hemolytic
S. pneumoniae is beta-hemolytic
Enterococci belong to Group D
16
Fill in the Blank
Fill in the blank: The major clinical group of streptococci associated with healthcare-associated infections is ___.
17

18
Multiple Choice
Which of the following is a key feature of Streptococcus pyogenes (Group A Strep)?
Bacitracin sensitivity
Gram-negative cocci
Catalase positive
Non-hemolytic
19

20
Open Ended
Describe the microscopic and colonial appearance of S. pyogenes and explain how these features aid in its identification in the laboratory.
21

22
Multiple Select
Which of the following are major virulence factors of S. pyogenes?
M protein
Hyaluronic acid capsule
Streptokinase
Catalase
23

24
Fill in the Blank
Streptolysin O and S are ___ that cause β-hemolysis in S. pyogenes infections.
25

26
Multiple Choice
Which clinical syndrome is most commonly associated with non-invasive S. pyogenes infection?
Pharyngitis
Necrotizing fasciitis
Bacteremia
Toxic shock syndrome
27

28
Open Ended
Compare and contrast acute rheumatic fever and post-streptococcal glomerulonephritis in terms of timing, pathogenesis, and clinical significance.
29

30
Multiple Choice
Which of the following is considered the gold standard for the laboratory diagnosis of S. pyogenes?
Rapid antigen test
Blood culture
Blood agar with bacitracin disk
ASO titer
31

32
Open Ended
Explain why adherence counseling is crucial in the treatment of S. pyogenes pharyngitis.
33

34
Multiple Select
Which of the following are key features of Streptococcus agalactiae (Group B Strep)?
CAMP test positive
α-hemolytic
Hippurate hydrolysis positive
β-hemolytic, Group B
35

36
Fill in the Blank
The screening protocol for Group B Strep in pregnant women involves rectal/vaginal swabs at ___ weeks of pregnancy.
37
38
Multiple Choice
Which laboratory characteristic distinguishes Groups C and G Streptococci from Group A Streptococci?
Optochin resistance
Bacitracin resistance
CAMP test positivity
α-hemolysis
39

40
Multiple Choice
Which clinical condition is most commonly associated with Viridans group streptococci?
Acute glomerulonephritis
Subacute endocarditis
Scarlet fever
Neonatal sepsis
41

42
Multiple Choice
Which group of Viridans streptococci is most commonly associated with dental caries?
S. mitis group
S. mutans group
S. anginosus group
S. bovis group
43

44
Multiple Select
Which of the following are clinical features or complications associated with subacute endocarditis caused by Viridans streptococci?
Abnormal or damaged valves
Gradual onset, slowly progressive
High mortality if untreated
Immediate onset and rapid progression
45

46
Fill in the Blank
Streptococcus pneumoniae is sensitive to ___, which helps differentiate it from other alpha-hemolytic streptococci.
47

48
Open Ended
Explain the significance of the polysaccharide capsule in Streptococcus pneumoniae and how it relates to vaccine development.
49

50
Multiple Choice
Which of the following factors contribute to the pathogenesis of S. pneumoniae?
Capsule prevents phagocytosis
Production of pneumolysin toxin
Ability to invade tissues
All of the above
51

52
Multiple Choice
Which clinical syndromes are commonly associated with S. pneumoniae infection?
Pneumonia, otitis media, meningitis
Cellulitis, hepatitis, conjunctivitis
Endocarditis, osteomyelitis, pancreatitis
Pharyngitis, gastroenteritis, arthritis
53

54

55

56

57

58

59

60

61

62

63

64

65

66

67

68

69

70

71

72

73

74

75

76

77

78
Multiple Choice
Which of the following is a pharmacy impact related to Streptococci and Enterococci?
Antibiotic selection and duration
Performing surgical procedures
Diagnosing viral infections
Administering chemotherapy
79
Open Ended
Summarize one key reason why understanding Streptococci and Enterococci is important for pharmacists.

Show answer
Auto Play
Slide 1 / 79
SLIDE
Similar Resources on Wayground

72 questions
Unit 1 Review
Lesson
•
9th - 12th Grade

73 questions
Marine Mammals 2
Lesson
•
9th - 12th Grade

71 questions
Abiotic vs Biotic
Lesson
•
6th - 8th Grade

74 questions
Pizza Fractions
Lesson
•
3rd Grade

73 questions
Macromolecules Part 1
Lesson
•
10th Grade

69 questions
Phase Change 1.2
Lesson
•
8th Grade

73 questions
Proportional Reasoning in Scale Drawings
Lesson
•
7th Grade

74 questions
04 Unit: Mexican National Era
Lesson
•
7th Grade
Popular Resources on Wayground

10 questions
5.P.1.3 Distance/Time Graphs
Quiz
•
5th Grade

10 questions
Fire Drill
Quiz
•
2nd - 5th Grade

20 questions
Equivalent Fractions
Quiz
•
3rd Grade

15 questions
Hargrett House Quiz: Community & Service
Quiz
•
5th Grade

20 questions
Main Idea and Details
Quiz
•
5th Grade

20 questions
Context Clues
Quiz
•
6th Grade

20 questions
Inferences
Quiz
•
4th Grade

15 questions
Equivalent Fractions
Quiz
•
4th Grade
Discover more resources for Science

16 questions
Parallel, Perpendicular, and Intersecting Lines
Quiz
•
KG - Professional Dev...

35 questions
World War Two 8th G
Quiz
•
6th Grade - Professio...

7 questions
DOL REC: Solutions & Solubility Curves
Quiz
•
Professional Development

20 questions
Block Buster Movies
Quiz
•
10th Grade - Professi...

20 questions
NCAA Logo Quiz
Quiz
•
Professional Development